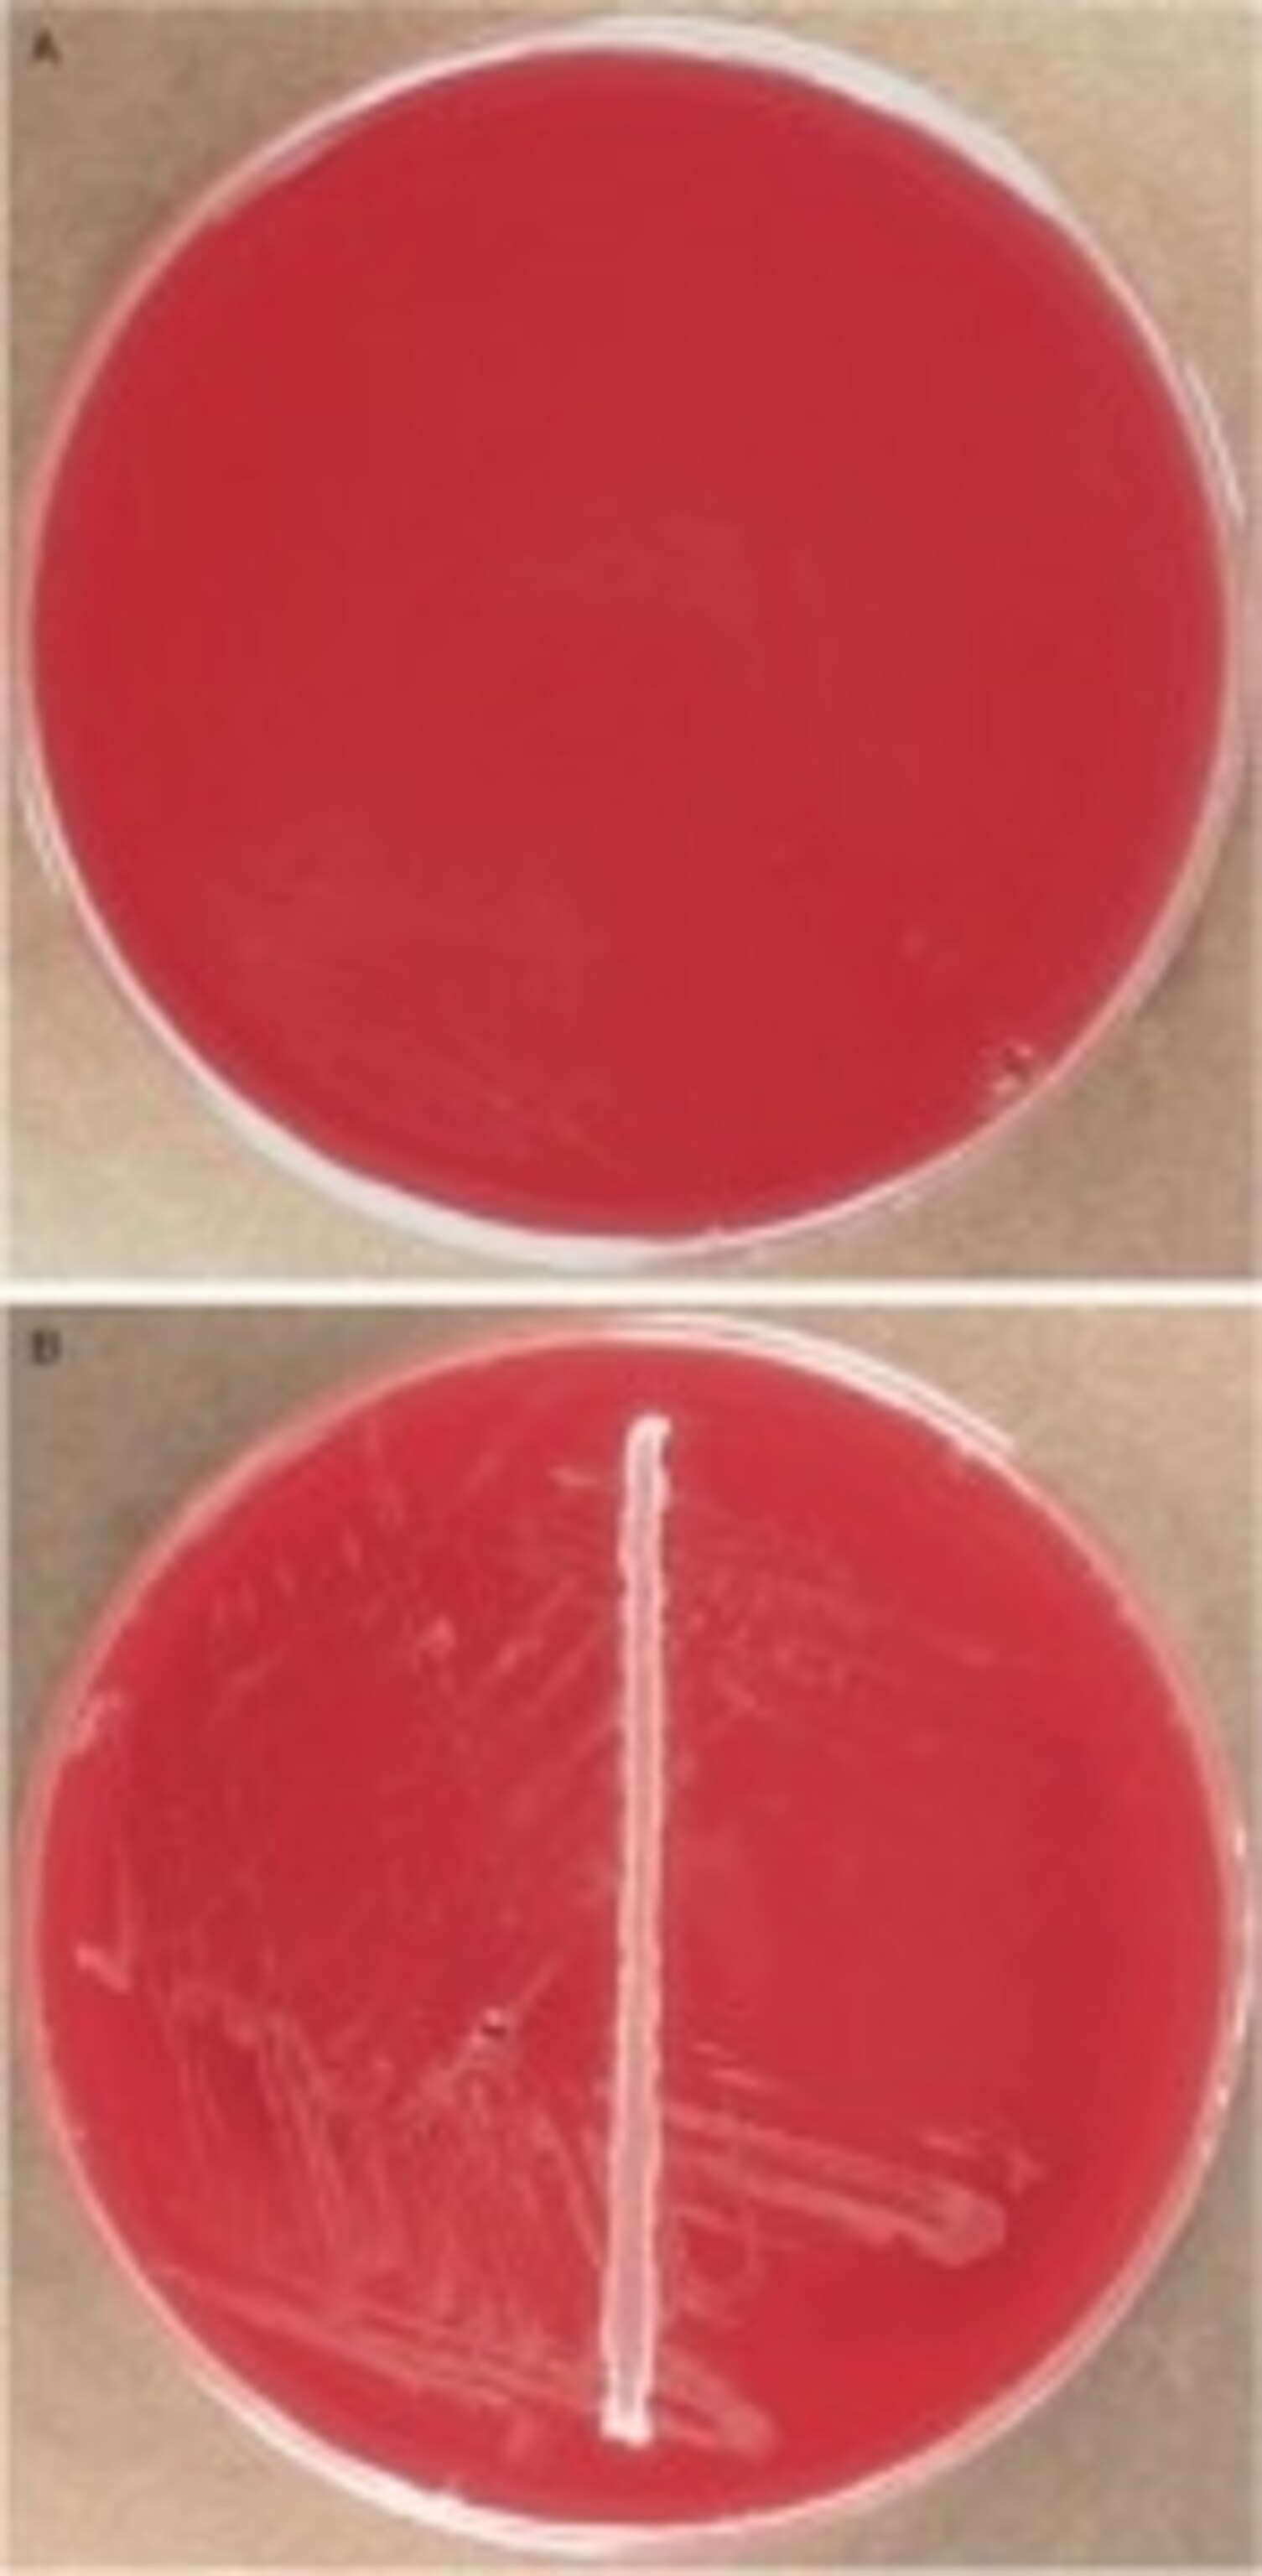

I went recently to San Francisco to give a talk to a conference of scientists. The scientists were experts in gathering together mountains of biological data—genome sequences, results of experiments and clinical trials—and figuring out how to make them useful: turning them into new diagnostic tests, for example, or a drug for cancer. The invitation was an honor, but a nerve-wracking one. As a journalist, I had no genome scan to offer the audience.
We science writers do have one ace in the hole, though. Instead of being lashed to a lab bench for years, carrying out experiments to illuminate one particular fold in one particular protein, we get to play the field. We travel between different departments, different universities, different countries, and—most important of all—different disciplines. And sometimes we see links between different kinds of science that scientists themselves have missed. Which is why, when I arrived in San Francisco, walked up to the podium, and switched on my computer, I presented my audience with this photograph of a lake.
For the next hour, I tried to convince them that their bodies are a lot like that lake, and that appreciating this fact could help them find new ways to treat diseases ranging from obesity to heart disease to infections of antibiotic-resistant bacteria.
The lake, called Linsley Pond, is located in southern Connecticut, a short drive east of New Haven. It’s about a half a mile wide. It supports a typical assortment of species, including algae and bacteria, water fleas, lily pads and other aquatic plants, birds, turtles, and fishes. It looks utterly ordinary. But in the history of ecology, it’s one of the most significant places on Earth.

If you were to have gone to the lake 70 years ago, you might have seen a gentleman swimming across the lake, holding a container of radioactive phosphorus, which he then dumped into the water. The swimmer’s name was G. Evelyn Hutchinson. Hutchinson is generally considered by ecologists to be the father of modern ecology. Before Hutchinson, ecology was, to a large extent, natural history. Naturalists would go out into the wild, catalog different species, and make a few observations. After Hutchinson, ecology became a science based on theory, based on mathematics, a science that asked fundamental questions about how nature works.

Lakes turned Hutchinson into a theoretician. They were like self-contained worlds, and Hutchinson was fascinated by the way different lakes in the same region could support different ecosystems. After he came to Yale in 1931, he began making regular trips to Linsley Pond with his students to run experiments, to figure out why this one lake had its particular balance of species. Hutchinson made Linsley Pond his laboratory flask.
Hutchinson and his students envisioned the life of Linsley Pond as embedded in an interplanetary flow of energy. The energy starts 93 million miles away, in the heart of the sun. It then hurtles through space, reaches Earth, plows through the atmosphere, and smashes into molecular traps laid out by the plants and algae in Linsley Pond.

The organisms tuck away some of that energy in their cells, while some of it is released as heat. Hutchinson and his colleagues traced the energy as it continued its flow through the lake’s ecosystem, as grazing zooplankton ate the algae, as larger animals fed on the smaller ones, as they died and were, in turn, scavenged by worms and bacteria.
As complicated as this diagram may look, Hutchinson knew that it was a faint shadow of the full picture. It’s not as if there is just one species of zooplankton. There are about 200 species of zooplankton, and maybe 1,000 species of algae.
Hutchinson realized that this diversity presents a paradox. Why should each part of a food web have so many species, rather than just one? Why doesn’t one species outcompete all the others for that spot? Why do we have food webs, instead of food chains?
The answer Hutchinson came up with is that species slice up an ecosystem in many ecological niches. People had talked about ecological niches before Hutchinson, but they used the word pretty crudely. A niche might just refer to the place where a particular species lived—where on a mountainside you might find a flower growing, say. Hutchinson had a much more sophisticated idea, one that shaped how ecologists think about diversity ever since.

A niche, Hutchinson proposed, was a slice of multidimensional space. One dimension might be the range of temperatures in which a species could survive. Another dimension might be the size of food particles an animal could fit in its mouth. If two species occupied different slices of ecological space, they wouldn’t overlap, and thus they wouldn’t directly compete with each other. Thanks to this ecological space, a food web can be loaded with seemingly identical species.

Even a lake as small as Linsley Pond offers a very complicated ecological space. This diagram shows the temperature, phosphorus concentrations, and other measurements as you go deeper down into the pond. At every depth, you find new niches. What’s more, those niches change over time. This graph shows oxygen and iron and phosphorus changing over the course of the seasons. Some species can adapt to the conditions that exist at one time of the year, while other specialize on other times.
But Hutchinson also recognized that the ecosystem in Linsley Pond was not some eternal cycle. Twenty thousand years ago, it didn’t even exist. Southern Connecticut was sitting under a glacier. When the ice retreated, it left behind gouged scoops. This particular scoop filled with fresh water and became a lake. It didn’t immediately become as it is today. It went through a process of what’s called ecological succession. There were certain species that could come into the lake quickly and take over open niches. But as they grew and reproduced, they changed the ecosystem itself. They were changing the chemistry of the lake, they were changing its transparency, they were adding to the sediment at the bottom when they died. The niches themselves changed, allowing new species to arrive in the lake and thrive.

Ecosystems seem to stick pretty closely to certain rules of succession. Lakes in the same region will tend to end up looking very much alike, even if you start with different species. But there’s a certain amount of luck involved, too. If the chemistry of the underlying rock and soil is different, different ecosystems will emerge. On remote islands, the mix of chance and fate is particularly striking. No land mammals ever arrived on the islands of Hawaii before humans, rats, and pigs. So there were no big predators there. On the other hand, even without mammals, Hawaii did give rise to big plant-grazers. Instead of cows, giant flightless geese filled that niche.
As ecosystems develop, they also become more resilient. They can withstand shocks to the system. A disease outbreak doesn’t bring it crashing down; it holds together even if one species becomes extinct. On the other hand, ecosystems aren’t infinitely resilient. If you push an ecosystem hard enough, it can flip to a new state.

Hutchinson and his colleagues were able to watch this kind of change in Connecticut lakes thanks to the comings and goings of a fish called the alewife. Before Europeans arrived, alewives were common to many Connecticut lakes, swimming into them each year to spawn. But dams and other changes to the land cut the fish off from many lakes, which became alewife-free. Later, as farming declined in New England, some dams came down, and fish started returning.


Hutchinson and his students realized that the return of alewives was a natural experiment. They measured the size of algae-grazing zooplankton before the arrival of alewives in a Connecticut Lake, and then afterwards. They saw a striking shift in the populations of the zooplankton. The alewives had wiped out the big ones, leaving the small ones to thrive. It was a big surprise at the time that a new species could exert such a powerful top-down effect on an ecosystem. And the effects extended beyond the zooplankton, since they changed the different sizes of algae and food particles that were getting eaten most.
We humans have also been changing Connecticut’s lakes. At Linsley Pond, for example, houses now line much of the lake’s edge. With the growing presence of humans, so comes greater erosion into the lake, and more nutrients like phosphorus. As a result, algae sometimes explode, clouding the once-clear lake.
Here, then, is one way of looking at life, at how the natural world works. I would wager most of it was fairly new to the people in my audience. They came from a different tradition—and one that was also coming in being seventy years ago, exactly at the same time Hutchinson was swimming around Linsley Pond. Meanwhile, a German refugee named Max Delbruck, was working in Tennessee, trying to get down to the essence of life—not in a lake, but in a Petri dish.


Delbruck came to the question from physics. He had studied with the great architects of quantum physics in the 1920s, and he became fascinated with living things from a physical point of view. How is it that they manage to retain so much order– not just through their lifetimes, but across generations? There was some understanding at the time that genes made all this possible. But nobody really knew what genes were. Many treated them as a mathematical abstraction, rather than physical things.
Delbruck speculated that a gene was some kind of polymer arising from some kind of repeating atomic structure. It was too small for Delbruck to handle, so he wanted to find an indirect way to study it. He was certainly not going to go to Linsley Pond and work with Hutchinson. To Delbruck, that was just chaos. He wanted to study genes in a single organism. He tried flies, but they were to big and messy for him. So he shrank his focus down even further, to viruses.
Delbruck couldn’t see viruses when he began his research in the late 1930s. Microscopes weren’t yet powerful enough. Instead, Delbruck developed a brilliant system of infecting E. coli with viruses. He would be able to measure the rate at which these viruses were infecting their hosts, just by look at the little pools of dead bacteria that grew over the course of hours.


This method allowed Delbruck to get clues to how viruses reproduced, and even how their genes mutated. By studying viruses and E. coli, he helped to build modern molecular biology. Delbruck’s influence radiated out from those initial experiments thanks to a summer course he ran at Cold Spring Harbor in New York. People like James Watson, shown here sitting on the ground at Cold Spring in 1953, learned genetics by studying Delbruck’s phages. The photo below was snapped just a few weeks after Watson and Francis Crick published their paper unveiling the structure of DNA.

Delbruck received a Nobel Prize in 1969 for his work, and when he gave his Nobel lecture, he felt fairly satisfied. “We may say in plain words, ‘this riddle of life has been solved,'” he declared.


The truth was that molecular biologists did not have just a few details left to sweep up. It would not be until 2001 that the human genome would finally be sequenced, and today, a decade later, those three and a half billion base pairs still hold on stubbornly to many mysteries. But even if we understood the function of every gene in the human genome, we would still not understand a great deal about how the human body works. That’s because the human body is not merely an oversize virus—simply a bundle of genes in a protein shell. We are, each of us, also a lake.
It is hardly news that the human body is an ecosystem. Over three centuruies have passed since Antony Von Leeuwenhoek scraped off some of the gunk from his teeth, mixed it in some water, put it under a microscope, and discovered “wee animalcules” swimming around in it. Ever since, scientists have tried to study the microbes that live in us and on us. But it hasn’t been easy.

In the late 1800s the German pediatrician Theodor Escherich wanted to find a better way to treat infants who were dying in droves from dysentery. He recognized that the bacteria that killing the babies were probably living alongside bacteria that weren’t harming them at all. He had to figure out the difference between them. Escherich got the stool out of healthy babies’ diapers and cultured their microbes. There was one bacteria that leaped forward, as if to say, “Me, me, me, look at me!” It now bears his name, Escherichia coli.
E. coli became such a publicity hound thanks to its ability to grow nicely in the oxygen in Escherich’s lab and to eat anything he gave it. He fed it blood, he fed it bread, he fed it potatoes. All were delicious to E. coli. Thanks to this eagerness, scientists began to use E. coli to ruis run many of their experiments on the fundamental nature of life (Delbruck included). And as a result, E. coli is arguably the best-understood life form on Earth. Yet this fame is completely undeserved. E. coli makes up only about .1% of the bacteria in a typical human gut.

These days scientists have a much clearer picture of our inner ecosystem. We know now that there are a hundred trillion microbes in a human body. You carry more microbes in you this moment than all the people who ever lived. Those microbes are growing all the time. So try to imagine for a moment producing an elephant’s worth of microbes. I know it’s difficult, but the fact is that actually in your lifetime you will produce five elephants of microbes. You are basically a microbe factory.
The microbes in your body at this moment outnumber your cells by ten to one. And they come in a huge diversity of species—somewhere in the thousands, although no one has a precise count yet. By some estimates there are twenty million microbial genes in your body: about a thousand times more than the 20,000 protein-coding genes in the human genome. So the Human Genome Project was, at best, a nice start. If we really want to understand all the genes in the human body, we have a long way to go.
Now you could say “Who cares? They’re just wee animalcules.” Those wee animacules are worth caring about for many reasons. One of the most practical of those reasons is that they have a huge impact on our “own” health. Our collection of microbes–the microbiome–is like an extra organ of the human body. And while an organ like the heart has only one function, the microbiome has many.
When food comes into the gut, for example, microbes break some of them down using enzymes we lack. Sometimes the microbes and our own cells have an intimate volley, in which bacteria break down a molecule part way, our cells break it down some more, the bacteria break it down even more, and then finally we get something to eat.
Another thing that the microbiome does is manage the immune system. Certain species of resident bacteria, like Bacteroides fragilis, produce proteins that tamp down inflammation. When scientists rear mice that don’t have any germs at all, they have a very difficult time developing a normal immune system. The microbiome has to tutor the immune system in how to do its job properly. It also acts like an immune system of its own, fighting off invading microbes, and helping to heal wounds.
While the microbiome may be an important organ, it’s a peculiar one. It’s not one solid hunk of flesh. It’s an ecosystem, made up of thousands of interacting species. To understand the microbiome, therefore, it helps to recall the principles that Hutchinson developed at Linsley Pond.

As I mentioned earlier, even a lake as small as Linsley Pond has an impressive diversity of species. Ecologists map patterns of diversity–both within ecosystems and between them. Scientists are doing that now in our own bodies. This figure is a survey of the diversity found in people’s noses. Each number is a different nose. Each one contains a couple hundred species of microbes; the colored bars show the different taxonomic groups to which they belong. This survey shows that there’s a huge amount of variation from one nose to the next.

Here’s a microbial Venn diagram shows the diversity in three mouths. All told, they harbor 818 species, but only 387 were shared by all three, the rest were missing from some people and present in others.
This sort of diversity is made possible thanks in part to the vast number of ecological niches in the human body. Microbes that live on the surface of the skin can get lots of oxygen, but they also bear the brunt of sun, wind, and cold. Microbes in the intestines have next to no oxygen, but they have a much more stable habitat. Microbes have carved up the human body into far finer niches. The bugs on your fingers are different from the ones on your elbow. The two sides of a single tooth have a different diversity of microbes.

The diversity of microbes in our bodies is also generated from their intimate interdependence. In some cases, they work together to break down food. In others, one species will change the chemical conditions in our bodies to support another one. As scientists figure out these partnerships, they are now able to rear many once-unrearable species.
Such is the case for one microbe called Synergistetes that lives in the mouth. On its own up in a Petri dish (the top red dish to the right), it struggles to grow. But if you add a streak of Parvimonas micra, it can take off. It’s not clear what P. micra is doing for Synergistetes but it’s doing something really important. There are links like this between the hundreds of species in every mouth.

Hutchinson recognized that Linsley Pond was ecologically born some 11,000 years ago and matured over the following millennia. When we are born, our bodies are also new ecological frontiers. Newborns are sterile, but they are promptly colonized, much like bacteria colonize other empty spaces, be they concrete, or a post-glacial landscape.

There’s an element of chance to how a baby’s ecosystem matures. How you’re delivered at birth determines the ecology of your skin. Babies delivered vaginally are coated in the bacteria that live in their mothers’ birth canal. Babies born by caesarian section end up with bacteria that live on the mother’s skin. But from these different starting points, our ecological succession converges on the same kind of profile. Toddlers end up with the same set of species on their skin.
The diversity of a baby’s ecosystem also increases over time. And this diversity is, itself, an important feature of the microbiome. It makes the ecosystem more resilient, and we benefit from that resilience. Scientists demonstrated how important diversity can be when they ran an experiment on mice. They lowered the diversity of microbes in the guts of mice and then exposed them to Salmonella. A low diversity of healthy microbe species made it easier for Salmonella to take hold and grow.
Microbes ward off invaders in many ways. They can clump onto pathogens, to prevent them from burrowing into host cells. They can form an impenetrable biofilm to shut out the competition. They can make toxins. They can send signals that effectively tell invaders just to calm down. In our mouths, they even make biosurfactants. In other words, our mouths are too slippery for pathogens to take hold.

When invaders to manage to get in, our ecosystem changes. Experiments have shown that when pathogens invade a mouse’s gut, the diversity of its residents drops. The effect is akin to what happened when alewives recolonized Connecticut lakes: they sent shock waves through the food webs. Another shock to our inner ecology comes from antibiotics. Antibiotics not only wipe out the pathogens that make us sick, but a lot of the ones that make us healthy. When antibiotics work, only the beneficial bacteria grow back. But the body’s ecosystem is different when it recovers, and it can remain different for months, or even years.
In the September 2010 issue of the journal Microbiology and Molecular Biology Reviews, a team of researchers looked over this sort of research and issued a call to doctors to rethink how they treat their patients. One of the section titles sums up their manifesto: “War No More: Human Medicine in the Age of Ecology.” The authors urge doctors to think like ecologists, and to treat their patients like ecosystems.

Recall, for example, how Hutchinson saw life in a lake as a flow of energy through a food web. For microbes, the energy doesn’t come from the sun (at least not directly). It comes from the food we eat. The energy flows into the microbes, into our own cells, and, in some cases, back to the microbes again. Microbes, it turns out, are at a strategic point in that flow, where they can influence how much energy we get from our foods. As a result, scientists have found, obese mice have a different microbial ecosystem than regular mice. And if you take the stool from one of these obese mice and transplant it into a mouse that has been raised germ-free, the recipient mouse will gain more weight than recipients of normal gut microbes. The microbes themselves are altering how obese mice are processing energy.
Obesity is just one medical disorder among many that the microbiome can influence. It’s also been linked inflammatory bowel disease, obesity, colon cancer, hypertension, asthma, and vascular disease. If we can manipulate our inner ecosystem, we may be able to treat some of these diseases.

Here’s one crude but effective example of what this kind of ecosystem engineering might look like. A couple years ago, Alexander Khoruts, a gastroenterologist at the University of Minnesota, found himself in a grim dilemma. He was treating a patient who had developed a runaway infection of Clostridium difficile in her gut. She was having diarrhea every 15 minutes and had lost sixty pounds, but Khoruts couldn’t stop the infection with antibiotics. So he performed a stool transplant, using a small sample from the woman’s husband. Just two days after the transplant, the woman had her first solid bowel movement in six months. She has been healthy ever since.
Khoruts and his colleagues later analyzed the microbes that were in the woman both before and after the transplant. Beforehand, her intestines were filled with a bizarre assortment of species, many of which are normally never seen in the gut. But soon after the stool transplant, those exotic species disappeared—along with the C. difficile. Her husband’s microbes took over.
It’s a remarkable success, but Khoruts and his colleagues can’t say exactly why it worked. He doesn’t know which of the hundreds of species that they delivered to the patient restored a healthy ecosystem in her gut. Eventually, scientists may come to understand the microbiome so well that they will be able to manipulate it with surgical precision, applying just a few species in a pill, or perhaps even just one keystone species.
But to know how to do that, they’ll have to explore the web of interconnections in our bodies, in the same way that ecologists can see a universe in a little lake.
[If you’ve reached the end of this monster blog post and want still more to read, check out The Art of Ecology: Writings of G. Evelyn Hutchinson, Good Germs, Bad Germs: Health and Survival in a Bacterial World, or my own book, Microcosm: E. Coli and the New Science of Life]

